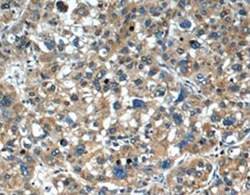

Rat Serpin A6 Antibody
Rat Serpin A6 Antibody Summary
Met1-Ala396
Accession # P31211
Applications
Please Note: Optimal dilutions should be determined by each laboratory for each application. General Protocols are available in the Technical Information section on our website.
Scientific Data
 View Larger
View Larger
Detection of Rat Serpin A6 by Western Blot. Western blot shows lysates of rat olfactory bulb tissue, rat liver tissue, rat brain (cerebellum) tissue, and rat brain (hippocampus) tissue. PVDF membrane was probed with 0.2 µg/mL of Mouse Anti-Rat Serpin A6 Monoclonal Antibody (Catalog # MAB3838) followed by HRP-conjugated Anti-Mouse IgG Secondary Antibody (Catalog # HAF018). A specific band was detected for Serpin A6 at approximately 50-60 kDa (as indicated). This experiment was conducted under reducing conditions and using Immunoblot Buffer Group 1.
 View Larger
View Larger
Serpin A6 in Rat Brain. Serpin A6 was detected in perfusion fixed frozen sections of rat brain (preoptic nucleus) using Mouse Anti-Rat Serpin A6 Monoclonal Antibody (Catalog # MAB3838) at 25 µg/mL overnight at 4 °C. Tissue was stained using the Anti-Mouse HRP-DAB Cell & Tissue Staining Kit (brown; Catalog # CTS002) and counterstained with hematoxylin (blue). Specific staining was localized to neurons. View our protocol for Chromogenic IHC Staining of Frozen Tissue Sections.
 View Larger
View Larger
Detection of Rat Serpin A6 by Simple WesternTM. Simple Western lane view shows lysates of Rat Cerebullum, rat liver, rat olfactory bulb, loaded at 0.2 mg/mL. A specific band was detected for Serpin A6 at approximately 88 kDa (as indicated) using 10 µg/mL of Mouse Anti-Rat Serpin A6 Monoclonal Antibody (Catalog # MAB3838). This experiment was conducted under reducing conditions and using the 12-230 kDa separation system.
Reconstitution Calculator
Preparation and Storage
- 12 months from date of receipt, -20 to -70 °C as supplied.
- 1 month, 2 to 8 °C under sterile conditions after reconstitution.
- 6 months, -20 to -70 °C under sterile conditions after reconstitution.
Background: Serpin A6
Serpin A6, also known as Corticosteroid-binding Globulin/CBG and Transcortin, is a 45‑60 kDa secreted glycoprotein member of the clade A serpin family of protease inhibitors. Although it is a serpin family member, it shows no protease inhibition. Serpin A6 is produced principally by hepatocytes, but is also expressed by hypothalamic neurons and anterior pituitary endocrine cells. Serpin A6 transports progesterone and > 90% of circulating cortisol, and likely has three functions: first it can be cleaved, releasing cortisol to the tissues; second, it regulates levels of free hormone available over time; and third, it likely binds to specific cell-surface receptors when complexed to cortisol. Mature rat Serpin A6 is 374 amino acids (aa) in length (aa 23‑396). It contains an RCL segment that is involved in steroid binding (aa 334‑351). Over aa 23‑396, rat Serpin A6 shares 78% and 60% aa sequence identity with mouse and human Serpin A6, respectively.
Product Datasheets
FAQs
No product specific FAQs exist for this product, however you may
View all Antibody FAQsReviews for Rat Serpin A6 Antibody
Average Rating: 5 (Based on 2 Reviews)
Have you used Rat Serpin A6 Antibody?
Submit a review and receive an Amazon gift card.
$25/€18/£15/$25CAN/¥75 Yuan/¥2500 Yen for a review with an image
$10/€7/£6/$10 CAD/¥70 Yuan/¥1110 Yen for a review without an image
Filter by: